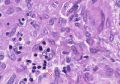

Wisteria
Hex Code, Palettes & Meaning

Wisteria (#C9A0DC) is a soothing, dreamy purple with subtle blue undertones that captures the essence of the wisteria flower's delicate cascading blooms. Named after the enchanting vine, this soft hue sits beautifully between blue and violet on the color wheel.
This elegant shade combines 78.8% red, 62.8% green, and 86.3% blue, creating a color psychology powerhouse that promotes tranquility and creativity. Interior designers particularly value wisteria for its calming properties, making it perfect for bedrooms, studies, and spa-like environments where relaxation is key.
Wisteria pairs harmoniously with champagne, mint green, and light gray for sophisticated palettes. For nature-inspired schemes, combine it with soft sage or cream tones. However, avoid pairing with intense colors like neon green or bright yellow, which can overwhelm its gentle nature.
Whether used in digital design, fashion, or home décor, wisteria brings an air of refinement and serenity that transforms any space into a sanctuary of elegant calm.
Color Palettes
Complementary
Split
Monochromatic
Analogous
Triadic
Hex
#C9A0DC
RGB
201,160,220
HSB
281, 27%, 86%
HSL
281, 46%, 75%
Other Colors

Jet black
Explore the qualities of Jet black.
Learn more

Light orange
Explore the qualities of Light orange.
Learn more

Khaki
Explore the qualities of Khaki.
Learn more

Platinum
Explore the qualities of Platinum.
Learn more

Electric blue
Explore the qualities of Electric blue.
Learn more

Fawn
Explore the qualities of Fawn.
Learn more